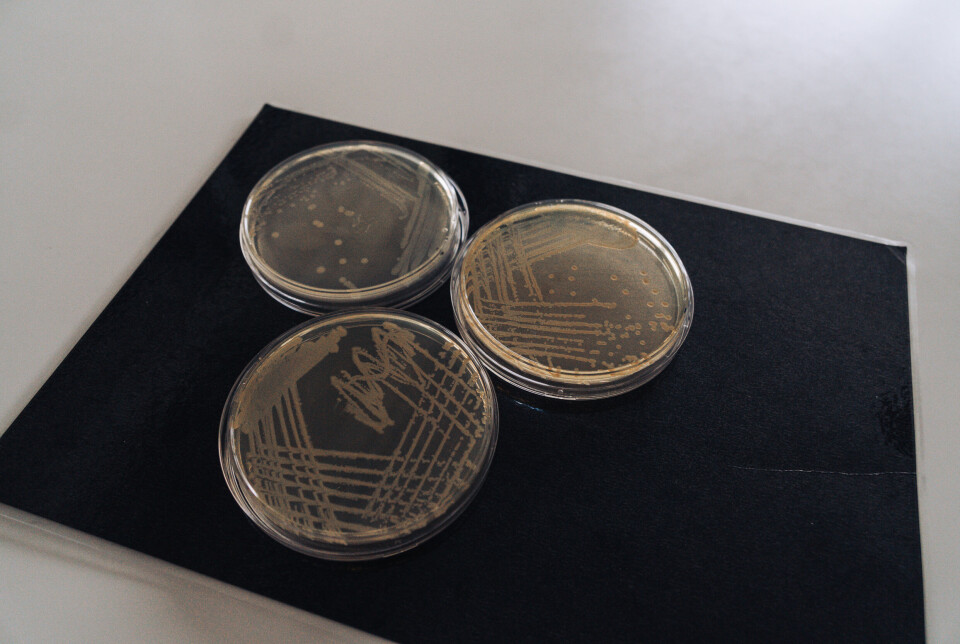

Denne artikkelen er produsert og finansiert av Havforskningsinstituttet - les mer.
Den nyoppdaga bakterien er kalla opp etter Havforskningsinstituttet.
Havet er fullt av bakteriar. Berre i ei t-skei med sjøvatn kan der vere så mange som fem millionar bakteriar. No er ein ukjend bakterie skildra for første gong – og døypt. (Foto: Erlend Astad Lorentzen / HI)
– Eg vurderte å kalle han Havforskningsinstituttet, men då vart namnet så langt, seier havforskar ved nettopp Havforskningsinstituttet (HI), Nachiket Marathe.
Han har nyleg skildra og dimed døypt ein heilt ny bakterie: Pseudomonas imrae.
Siste del av namnet, med bokstavane imr, er til ære for HI. På engelsk heiter det Institute of Marine Research (IMR).
Aldri tidlegare studert
Den nyoppdaga bakterien vart funnen i mageprøver frå makrell, som vart fangsta i Nordsjøen i november 2018.
Forskar Marathe er den første til å ha isolert og studert bakterien.
– Innanfor bakterie-verda har vi ei rekkje standardiserte metodar som let oss klassifisere kva bakterie vi har med å gjere. Men denne passa ikkje fullt inn nokon stad – endå enkelte av gen-sekvensane hans hadde over 90 prosent overlapp med andre bakteriar vi kjenner.

Bakterien vart isolert frå mageprøver frå makrell, fangsta i Nordsjøen. (Illustrasjonsfoto: Leif Nøttestad / Havforskingsinstituttet)
Dette er ganske typisk for bakteriar som høyrer til slekta Pseudomonas: Dei er kompliserte å klassifisere. Dei kan dele mange fellestrekk med kvarandre, men likevel vere noko heilt særeige.
Bakterien var med andre ord eit uskrive blad. Det er då arbeidet startar for alvor.
Sjølv den minste mikrobe kan spele ei stor rolle
Havforskingsdirektør Nils Gunnar Kvamstø gler seg over den nydøypte bakterien – både namnet, men òg arbeidet som ligg bak at han no er skildra.
– Det er ingenting som er så kjekt som at forskarane våre utmerkjer seg og set sitt preg både nasjonalt og internasjonalt. Det viser at HI er der vi vil vere – vi skal drive verdsleiande havforsking.
Kvamstø peikar på at havet og dei marine økosystema er samansett. Kvar organisme spelar ei unik rolle – anten det er spekkhoggarar, sild, korallar eller mikrobar.
Bakteriar er funne på dei mest utrulege stader: i Marianegropa – havets djupaste område, på over 11.000 meter – under isen i Antarktis og i sediment fleire hundre meter under havbotnen.
Dei fleste bakteriar er ufarlege og heilt nødvendige for eit friskt og produktivt hav.
– Alle ledd i næringskjedene og økosystemet heng saman og er avhengige av kvarandre, seier Kvamstø og held fram:
– Difor er det viktig å også få meir kunnskap om dei minste bestandsdelane. Særleg i ei tid der det veks fram fleire interesser til havs. Det vert meir press på økosystema og klimaendringane kjem inn som ein joker. Sjølv den minste mikrobe kan kome til å spele ei stor rolle.
Tallaust med ukjende bakteriar
Den nyskildra P. imrae vart isolert av Marathe i 2018. Åra sidan har gått med til å utføre ein drøss ulike eksperiment i ledige stunder mellom andre prosjekt.
– Det er eit kolossalt kvelv av ukjende bakteriar, særleg i marine miljø. Men ved HI har vi metodane for å isolere og skildre dei, seier havforskaren og held fram:
– Vi finn stadig fleire nye bakteriar, og å karakterisere desse er viktig – men det tek òg tid.
Ein kan ikkje identifisere ein bakterie ut frå korleis han ser ut, frå ulikskapar og karakteristikkar på overflata. Forskarane lyt gjere eksperiment etter eksperiment:
Bakteriar som høyrer til slekta Pseudomonas er utbreidde i akvatiske miljø. (Foto: Erlend Astad Lorentzen)
Kva karbon- og energikjelder utnyttar bakterien? Kva andre avfallsstoff produserer han? Produserer han syre eller gass? Kva feittsyrer har bakterien? Kva temperatur trivst han i?
Kva salt-konsentrasjon treng han for å vekse? Korleis ser DNA-sekvensane ut? Kva med heile genomet? Kva antibiotika reagerer han på og kva er han resistent mot?
Marathe går igjennom nokre av undersøkingane dei har gjennomført for å ende opp med fasit på kva bakterie dette er og kva eigenskapar han har.
– Eksperimentlista er nesten endelaus, seier havforskaren.
Vert alltid oversett
Det kan vere langtekkeleg arbeid å skildre bakteriar. Det vankar ikkje nødvendigvis så mykje heider og ære for innsatsen. Likevel er Nachiket Marathe klar på at han synest det er meiningsfullt arbeid.
– Når vi karakteriserer ein bakterie, hjelper det oss å forstå rolla denne har i økosystemet.

Slik ser HI-bakterien ut i eit avansert mikroskop. (Foto: HI)
Havforskaren peikar på at mellom 70 og 90 prosent av all biomassen i havet, altså massen av levande organismar, er nettopp mikrobar.
– Det er meir bakteriar i havet enn det er fisk. Desse er ein stor del av økosystemet: Mikrobane bryt ned daudt organisk materiale, resirkulerer næringsstoffa og held økosystemet i gang. Men dei vert alltid oversett.
Oppdaga ny bakterie i eigen mage
Det er ikkje berre i makrellmagen Marathe har funne ukjende bakteriar. Det same har han faktisk funne i sin eigen mage:
– Som doktorgradsstudent brukte eg prøver frå meg sjølv i eit prosjekt vi hadde. Det var litt for moro skuld, men eg isolerte ein ny bakterie.
Denne kalla Marathe opp etter heimlandet sitt: Megasphaera indica.
Tidlegare har han også karakterisert og gitt namn til ei ny slekt bakteriar. Desse vart isolerte frå svenske pasientar med infiserte sår og er kalla opp etter Skandinavia og Göteborg: Scandinavium goeteborgense.
Endå har Marathe nokre uskildra bakteriar på lager som han skal introdusere for verda, når tida strekker til.
Ifølgje havforskaren er boka over alle bøker innan mikrobiologien Bergey's Manual of Systematic Bacteriology.
– Det er som vår «bibel». Når du har publisert ei taksonomisk skildring av ein bakterie, så vert denne lagt til i manualen. Plutseleg er du ein del av bakteriebibelen.
Referanse:
Salvà-Serra Francisco, Marathe Nachiket P. mfl.: Description of Pseudomonas imrae sp. nov., carrying a novel class C β-lactamase gene variant, isolated from gut samples of Atlantic mackerel (Scomber scombrus). Frontiers in Microbiology , 2025. DOI: 10.3389/fmicb.2025.1530878